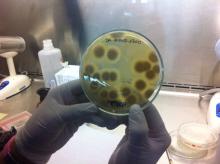
Hongos Patógenos  cultivo y tinción
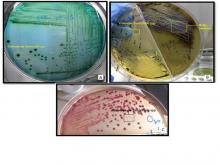
Salmonellosis  cultivo

Mediante la simplificación de trámites buscamos: mejorar la calidad de vida de los ciudadanos, ahorrando tiempo en la realización de trámites, tener un gobierno más eficiente al reducir recursos que se gastan en la prestación de trámites presenciales y limitar la corrupción al eliminar la discrecionalidad en los procesos.
Los trámites en línea son más rápidos (un 74% en promedio), más baratos de prestar (cuestan entre el 1,5% y el 5% de lo que cuestan los trámites presenciales) y menos vulnerables a la corrupción. (Latinobarómetro, 2017).

|
Solicitud de análisis de muestra Gumboro Aviar ELISAAgencia de Regulación y Control Fito y ZoosanitarioTrámite orientado a realizar el diagnóstico de la enfermedad de Gumboro mediante la técnica ELISA indirecto. La enfermedad de Gumboro o enfermedad de bursitis infecciosa es una enfermedad altamente contagiosa de pollos jóvenes causada por el virus de la enfermedad de bursitis infecciosa, ... |

|
Solicitud de análisis de muestra Mycoplasma gallisepticum Aviar ELISAAgencia de Regulación y Control Fito y ZoosanitarioTrámite orientado a realizar el diagnóstico de anticuerpos contra Mycoplasma gallisepticum en aves mediante la técnica ELISA indirecto. Mycoplasma gallisepticum (MG), son dos de los patógenos más importantes en la industria avícola. La infección puede cursar con signos muy variables,... |

|
Solicitud de análisis de muestra de NEWCASTLE mediante técnica ELISAAgencia de Regulación y Control Fito y ZoosanitarioTrámite orientado a la determinación de anticuerpos contra la enfermedad de NEWCASTLE en aves mediante técnica ELISA indirecto. La enfermedad de Newcastle es una infección altamente contagiosa y con frecuencia severa que existe en todo el mundo y afecta a las aves,... |
|
Solicitud de análisis de muestra Hongos Patógenos cultivo y tinciónAgencia de Regulación y Control Fito y ZoosanitarioTrámite orientado al diagnóstico de hongos patógenos (mohos y levaduras) en animales domésticos, mediante cultivo e identificación. Emisión de resultado de análisis, para la detección oportuna de enfermedades o problemas, para la aplicación de medidas adecuadas para la prevención, control y... |

|
Solicitud de análisis de muestra Camphylobacter cultivo bioquímicaAgencia de Regulación y Control Fito y ZoosanitarioTrámite orientado al diagnóstico de Campylobacter sp. mediante cultivo bacteriano y pruebas bioquímicas, emisión de resultado de análisis, para la detección oportuna de enfermedades o problemas, para la aplicación de medidas adecuadas para la prevención, control y atención de las mismas. |

|
Solicitud de análisis de muestra Septicemia Hemorrágica cultivo bioquímicaAgencia de Regulación y Control Fito y ZoosanitarioTrámite orientado al diagnóstico de Septicemia Hemorrágica (Pasteurella multocida) mediante cultivo bacteriano y pruebas bioquímicas, Emisión de resultado de análisis, para la detección oportuna de enfermedades, problemas o patógenos, para la aplicación de medidas adecuadas para la prevención,... |

|
Solicitud de análisis de muestra Enterobacterias cultivo bioquímicaAgencia de Regulación y Control Fito y ZoosanitarioTrámite orientado al diagnóstico de Enterobacterias mediante cultivo bacteriológico y pruebas bioquímicas. Emisión de resultado de análisis, para la detección oportuna de enfermedades o problemas, para la aplicación de medidas adecuadas para la prevención, control y atención de las mismas.... |

|
Solicitud de análisis de muestra Leptospirosis Microaglutinación en tuboAgencia de Regulación y Control Fito y ZoosanitarioTrámite orientado al diagnóstico de Leptospirosis mediante la técnica Microaglutinación en tubo. Emisión de resultado de análisis, para la detección oportuna de enfermedades o problemas, para la aplicación de medidas adecuadas para la prevención, control y atención de las mismas. |
|
Solicitud de análisis de muestra Salmonellosis cultivo bioquímicaAgencia de Regulación y Control Fito y ZoosanitarioTrámite orientado al diagnóstico de Salmonellosis mediante cultivo bacteriano, pruebas bioquímicas y serotipificación con antisueros, emisión de resultado de análisis, para la detección oportuna de enfermedades o problemas, para la aplicación de medidas adecuadas para la prevención,... |

|
Solicitud de análisis de muestra Estafilococos cultivo-bioquímicaAgencia de Regulación y Control Fito y ZoosanitarioTrámite orientado al diagnóstico de Estafilococosis y otras patologías causadas por cocos, mediante cultivo bacteriano y pruebas bioquímicas, emisión de resultado de análisis, para la detección oportuna de enfermedades o problemas, para la aplicación de medidas adecuadas para la... |
| |
Solicitud de análisis de muestra Hemoparásitos GiemsaAgencia de Regulación y Control Fito y ZoosanitarioTrámite orientado al diagnóstico de Hemoparásitos mediante tinción de Giemsa, con el objetivo de detectar oportunamente parásitos sanguíneos que afectan a los animales. Esta acción permite implementar medidas eficaces de prevención, control y erradicación de enfermedades hemoparasitarias,... |

|
Solicitud de análisis de muestra Mycobacterias ZIELH NEELSENAgencia de Regulación y Control Fito y ZoosanitarioTrámite orientado al diagnóstico de Mycobacterias mediante tinción ZIELH NEELSEN. Emisión de resultado de análisis, para la detección oportuna de enfermedades o problemas, para la aplicación de medidas adecuadas para la prevención, control y atención de las mismas. ... |

|
Solicitud de análisis de muestra Influenza Porcina H1N1 ELISAAgencia de Regulación y Control Fito y ZoosanitarioTrámite orientado al Diagnóstico de Influenza Porcina tipo A mediante la técnica ELISA, para la detección oportuna de anticuerpos contra patógenos causantes de enfermedades en animales con la finalidad de aplicar medidas adecuadas de prevención, control y erradicación de problemas... |

|
Solicitud de análisis de muestra Peste Porcina Clásica ELISA AcAgencia de Regulación y Control Fito y ZoosanitarioTrámite orientado al diagnóstico de Peste Porcina Clásica mediante la técnica ELISA, para la detección oportuna de anticuerpos contra patógenos causantes de enfermedades en animales con la finalidad de aplicar medidas adecuadas de prevención, control y erradicación de problemas... |

|
Solicitud de análisis de muestra Peste Porcina Clásica ELISA AgAgencia de Regulación y Control Fito y ZoosanitarioTrámite orientado al diagnóstico de Peste Porcina Clásica mediante la técnica ELISA, para la detección oportuna del antígeno causante de la enfermedad en animales con la finalidad de aplicar medidas adecuadas de prevención, control y erradicación de problemas zoosanitarios, contribuyendo al... |

|
Solicitud de análisis de muestra Neumonía Enzootica Porcina My hyop ELISAAgencia de Regulación y Control Fito y ZoosanitarioTrámite orientado al diagnóstico de Neumonía Enzoótica Porcina, Mycoplasma hyopneumoniae, mediante la técnica ELISA, para la detección oportuna de anticuerpos contra patógenos causantes de enfermedades en animales con la finalidad de aplicar medidas adecuadas de prevención,... |

|
Solicitud de análisis de muestra Circovirus Porcino Tipo II ELISAAgencia de Regulación y Control Fito y ZoosanitarioTrámite orientado al diagnóstico de Circovirus Porcino Tipo II mediante la técnica ELISA, se enfoca en la detección oportuna de anticuerpos contra patógenos causantes de enfermedades en animales con la finalidad de aplicar medidas adecuadas de prevención, control y erradicación de problemas... |

|
Solicitud de análisis de muestra Síndrome Disgenésico y Respiratorio Porcino PRRS ELISAAgencia de Regulación y Control Fito y ZoosanitarioTrámite orientado al diagnóstico de Síndrome Disgenésico y Respiratorio Porcino, PRRS mediante la técnica ELISA, se enfoca en la detección oportuna de anticuerpos contra patógenos causantes de enfermedades en animales con la finalidad de aplicar medidas adecuadas de prevención, control... |

|
Solicitud de análisis de muestra Pseudorabia Porcina Aujeszky ELISAAgencia de Regulación y Control Fito y ZoosanitarioTrámite orientado al diagnóstico de Pseudorabia o enfermedad de Aujeszky mediante la técnica ELISA, para la detección oportuna de anticuerpos contra patógenos causantes de enfermedades en animales con la finalidad de aplicar medidas adecuadas de prevención, control y erradicación de... |

|
Solicitud de análisis de muestra Erisipela Porcina Erysipelothrix rhusiopathiae ELISAAgencia de Regulación y Control Fito y ZoosanitarioTrámite orientado al diagnóstico de Erisipela Porcina Rysipelothrix rhusiopathiae mediante la técnica ELISA, se enfoca en la detección oportuna de anticuerpos contra patógenos causantes de enfermedades en animales con la finalidad de aplicar medidas adecuadas de prevención, control y... |

|
Solicitud de análisis de muestra Gastroenteritis Transmisible Porcina ELISAAgencia de Regulación y Control Fito y ZoosanitarioTrámite orientado al diagnóstico de Gastroenteritis Transmisible Porcina mediante la técnica ELISA, se enfoca en la detección oportuna de anticuerpos contra patógenos causantes de enfermedades en animales con la finalidad de aplicar medidas adecuadas de prevención, control y... |

|
Solicitud de análisis de muestra de Diarrea epidémica porcina pcr convencionalAgencia de Regulación y Control Fito y ZoosanitarioTrámite orientado al Diagnóstico de Diarrea epidémica porcina mediante la técnica de PCR convencional. Los ensayos de detección que se realizan mediante PCR permiten identificar la presencia o ausencia del patógeno al detectar su ácido nucleico en la muestra. La técnica de PCR presenta... |

|
Solicitud de análisis de muestra Coproparasitario Frotis DirectoAgencia de Regulación y Control Fito y ZoosanitarioTrámite orientado al diagnóstico de parasitosis gastrointestinales mediante la técnica de frotis directo, que permite la detección rápida y preliminar de formas evolutivas como trofozoítos, quistes, huevos y larvas de protozoarios y helmintos. Es una herramienta complementaria útil en... |

|
Solicitud de análisis de muestra Coproparasitario ConcentraciónAgencia de Regulación y Control Fito y ZoosanitarioTrámite orientado al diagnóstico de parasitosis gastrointestinales en grandes especies animales mediante la técnica Coproparasitaria de concentración por flotación, la cual permite detectar con alta sensibilidad estructuras parasitarias como huevos y quistes, separándolas del material fecal... |

|
Solicitud de análisis de muestra Trichomoniasis Frotis DirectoAgencia de Regulación y Control Fito y ZoosanitarioTrámite orientado al diagnóstico de Trichomoniasis mediante la técnica de Frotis Directo en material procedente de lavado genital, se enfoca en la detección oportuna de patógenos causantes de enfermedades en animales con la finalidad de aplicar medidas adecuadas de prevención, control y... |